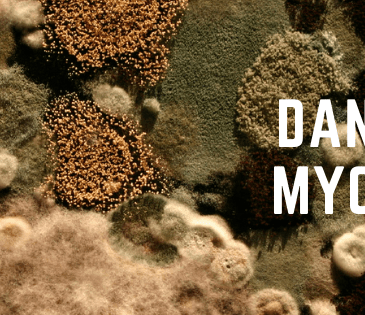

When the Fire Feels Like Failure
When the mind feels like it’s burning out, God might just be refining what’s real.
Jeremiah’s story reminds us that the breakdown is not always the end. Sometimes it is the fire between who we were and who we are becoming. … More When the Fire Feels Like Failure